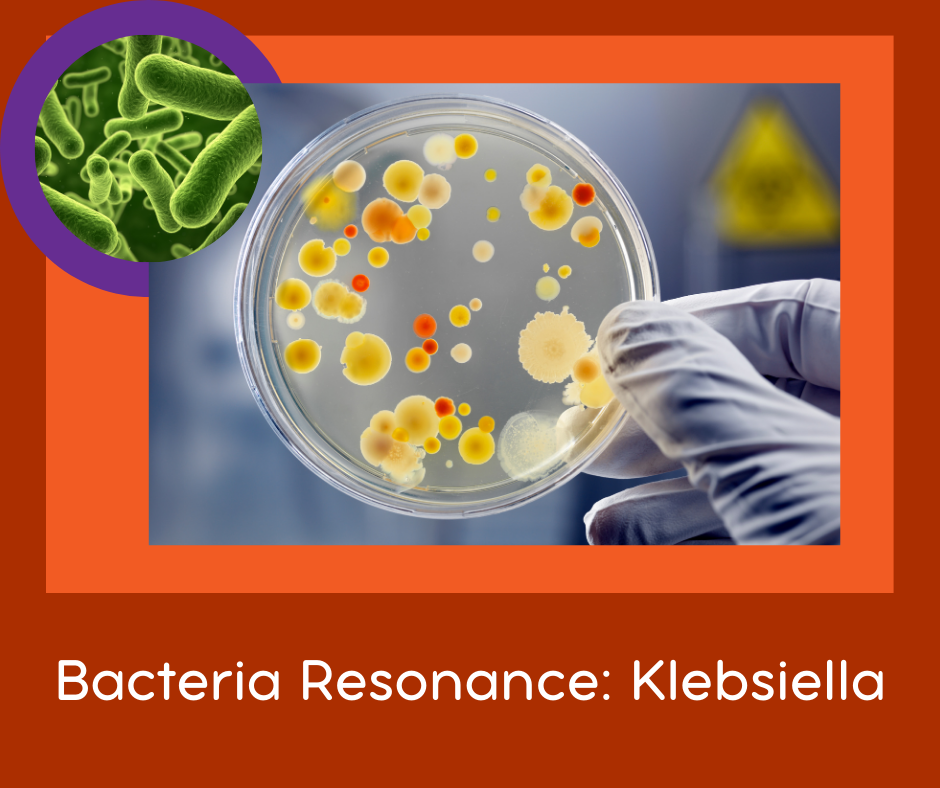

FSR's for Bacterial Infections: Klebsiella
FSR's are sound files that, when played on your body, influence the vibration of your body. The result of this is that your system can have a positive change in response to the sound.
This is the Resonance Treatment #1 for Klebsiella.
Klebsiellae are non-motile, rod-shaped, gram-negative bacteria with a prominent polysaccharide capsule. This capsule encases the entire cell surface, accounts for the large appearance of the organism on gram stain, and provides resistance against many host defense mechanisms. It is often hard to eradicate.
I would be a good idea to use the FSR's for Bacterimia as well.
Place where you need it - most common place is over lungs. Play for 30 minutes if possible.
Official Name: Klebsiella Pnuemonia

